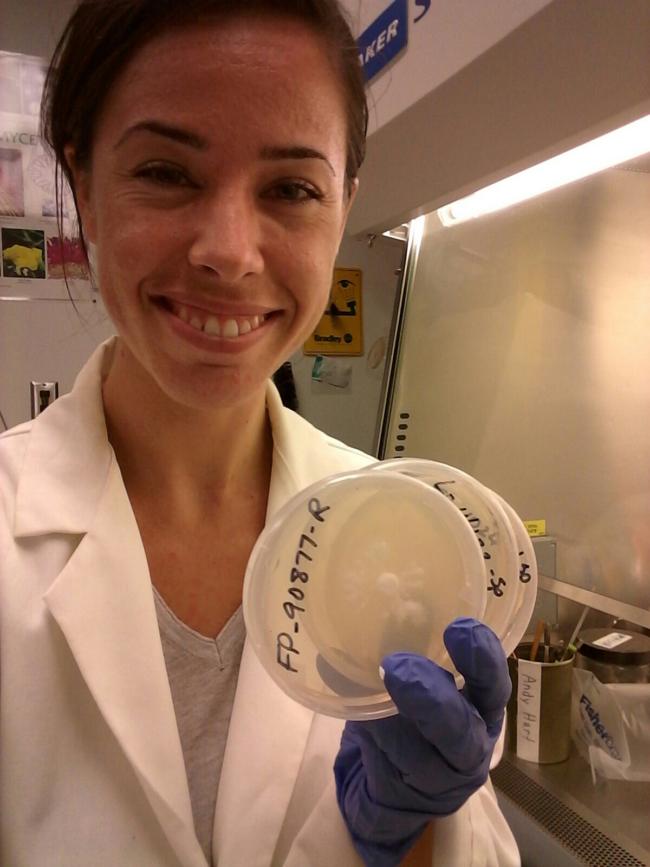

107
0
0
Like?
Please wait...
About This Project
Mycoremediation is a form of bioremediation that uses fungi to clean up contaminated sites. Brown rot and white rot are categories of fungi that produce different suites of digestive enzymes that have each shown potential for mycoremediation. We aim to bolster the efficiency of mycoremediation techniques currently in use by combining white rot and brown rot fungi to produce a broader arsenal of digestive enzymes to break down diesel in contaminated soils.

Browse Other Projects on Experiment
Related Projects
Biomapping of Tree-based Atmospheric Methane Removal (TAMR) for Technological Development
Tree surfaces can be an effective approach for AMR, although foundational information is lacking. Here...
Mercury is in our fog, so what about our food?
Near-toxic levels of mercury were recently discovered in the fur of mountain lions in the mountains of coastal...
Can brown rot and white rot fungi work together to clean up spilled diesel?
Mycoremediation is a form of bioremediation that uses fungi to clean up contaminated sites. Brown rot and...